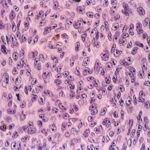

Nodular melanoma = الميلانوم العقيدي
|
Common Tumorigenic Melanoma Including Nodular Melanoma Nodular melanoma by definition contains only tumorigenic vertical growth (sometimes associated with a precursor) and, because of this, has a poorer prognosis on the average than superficial spreading melanoma. However, when other risk factors such as thickness are controlled, the prognosis of nodular melanoma is not worse than that of other forms of melanoma . Nodular melanomas occur in slightly older patients than the common superficial spreading melanoma and are relatively more frequent in men . A nodular melanoma starts as an elevated, variably pigmented papule that increases in size quite rapidly to become a nodule and often undergoes ulceration. Certain rare primary dermal melanomas comprised of cytologically malignant melanocytes and lacking an in situ |
|
component may be considered also in this category . The ABCD criteria reviewed earlier do not apply to nodular melanomas, which often present clinically as quite small, symmetric, and well-circumscribed papules or nodules . These may be conspicuously pigmented, oligomelanotic, or even amelanotic. The tumorigenic nodule that may develop in nodular melanoma does not differ clinically or histologically from that which may occur in relation to a preexisting nontumorigenic melanoma. Indeed, nodular melanomas may represent examples of telescoped tumor progression in which the antecedent radial phase has been so short lived as to be unapparent . The clinical importance of the nodular subtype has been emphasized recently; these lesions are more likely to present at a biologically advanced stage despite a comparatively short clinical history . The mutation profile of nodular melanoma is closer to that of superficial spreading melanoma than to the other subtypes, in that BRAF or NRAS are commonly mutated . |
|
Histopathology of Nodular Melanoma and Common Vertical Growth Phase (Tumorigenic Melanoma) Architectural Features. In a typical tumorigenic melanoma, there is contiguous proliferation of neoplastic melanocytes in the dermis forming a tumor mass that is larger (usually much larger) than the largest nest in the |
|
Perhaps the best-known single criterion for melanoma is the upward pagetoid extension of tumor cells into the epidermis overlying the melanoma. However, this pagetoid melanocytosis or pagetoid spread is not specific for melanoma (152). Although in nodular melanoma, permeation of the epidermis with tumor cells may be absent or may be limited to that portion overlying the dermal tumor, lateral extension of melanoma cells in the epidermis and papillary dermis beyond the confines of the dermal tumor is seen in the adjacent nontumorigenic compartment of complex primary melanomas [SSM, LMM, acral-Ientiginous melanoma (ALM)]. This phenomenon greatly aids in histologic recognition of these tumors, and, conversely, the recognition of nodular melanomas, which lack this adjacent component, may be difficult. For this reason, nodular melanoma may be difficult or impossible to distinguish from a metastatic melanoma in the skin, and when such a tumor is amelanotic, the distinction from other cutaneous neoplasms may be impossible without immunohistochemistry. |
|
The amount of inflammatory infiltrate in tumorigenic melanomas varies. As a rule, early invasive malignant and many in situ melanomas show a bandlike inflammatory infiltrate, often intermingled with melanophages, at the base of the tumor. In tumors that extend deep into the dermis, the inflammatory infiltrate is quite variable, but it is often only slight to moderate rather than pronounced. Lymphocytes extending among tumor cells are often associated with morphologic evidence of damage to individual tumor cells (apoptosis). These tumor-infiltrating lymphocytes (TILs) have been shown to have independent favorable prognostic significance . The infiltrate is a predominantly T-cell response . TILs extracted from melanomas (mostly metastatic cases) may be cytotoxic and may be directed against immunogenic melanoma-associated antigens . |
|
Cytological Features. The tumor cells in the dermis show great variation in size and shape. Nevertheless, two major types of cells can be recognized; an epithelioid and a spindle-shaped cell type. Many tumors show both types of cells, but usually one type predominates. Generally, the lentiginous forms of melanoma (e.g., LMM and ALM) tend to show a predominance of spindle-shaped cells in their invasive dermal components, whereas superficial spreading and nodular melanomas tend to be composed largely of epithelioid cells . The epithelioid type of cell tends to lie in alveolar or nested formations and the spindle-shaped type of cells in irregularly branching formations. The alveolar formations of the epithelioid cells are surrounded by thin fibers of collagen containing a few fibroblasts. Tumors in which spindle cells predominate may resemble sarcomas or other spindle cell tumors but in most cases differ from them by the presence of junctional melanocytic activity. |
|
The uniformly atypical nuclei of the cells that constitute the tumor nodule are larger than those of melanocytes or nevus cells, with irregular nuclear membranes, hyperchromatic chromatin, and, often, prominent nucleoli that tend to be irregular in size, shape, and number. The atypia is considered to be uniform if more than 50% of the cells have these |
|
characteristics, but more often than not, all or most of the cells are atypical. In addition to this uniform moderate or severe cytologic atypia, there is also a diagnostically important failure of the melanocytes in the deeper layers of the dermis to decrease in size (absence of maturation) . This must not be confused, however, with the presence of an intradermal nevus beneath a melanoma, a fairly common feature. Not uncommonly, melanoma cells will recapitulate nevic cell maturation (so-called pseudomaturation), but in these instances the smaller cells at the base retain nuclear characteristics of malignant cells, and there will be cytologic continuity between these nevoid cells and the overlying more atypical lesional cells. |
|
Mitotic figures are usually present in the lesional cells of the dermal and epidermal compartments of tumorigenic melanomas [they are present in the epidermal lesional cells in about one third of nontumorigenic melanomas and in the dermal compartment of 85% of tumorigenic melanomas . Mitoses may also be seen in adjacent hyperplastic keratinocytes. The nuclei of these hyperplastic epidermal keratinocytes may be enlarged with prominent nucleoli, although they are not irregular or hyperchromatic. In contrast, mitotic figures are rarely seen in |
|
benign nevi other than Spitz nevi, and even in the latter lesions the rate is usually low or zero . |
|
Differential Diagnosis. Great difficulty may be encountered in the differentiation of a nodular melanoma from an atypical dermal or compound nevus. The actual incidence of a wrong diagnosis is not inconsiderable, judging from the frequency with which pathologists disagree in their opinions. When there is doubt, the uncertainty should be acknowledged and the differential diagnosis should be clearly indicated so that appropriate therapeutic intervention can be planned. Incisional biopsies are a common source of interpretive difficulty. The site of melanocytic lesions that have been partially removed by shave or punch biopsy should be excised to assure complete removal if there is any doubt at all about the diagnosis. |
|
The most important attributes that differentiate the tumorigenic vertical growth phase of melanoma from nevi include asymmetry, lack of maturation of lesional cells with descent into the dermis, mitotic activity, and uniform cytologic atypia. Apoptotic tumor cells, which often accompany mitotically active lesions, may also be of assistance. |
|
The most important differential diagnostic consideration for nodular melanoma is the Spitz nevus. The criteria for this distinction are presented in Table 28-3 and discussed in the section Spitz Nevus. |
|
In some instances, it may be difficult to recognize a highly undifferentiated melanoma as such. The specific identification of a tumor as melanoma depends on the identification of melanin or on appropriate immunohistochemical reactivity in an appropriate setting. The amount of melanin present varies greatly in melanomas. In some tumors, considerable melanin is found not only within the tumor cells, but also within melanophages located in the stroma. In others, there may be no evidence of melanin in hematoxylin-eosin stains. However, a Fontana-Masson silver stain usually reveals at least a few cells containing melanin . Some melanomas are completely devoid of pigment (amelanotic melanoma). Although amelanotic melanomas tend to be aggressive lesions, the prognosis is not different from that of pigmented melanomas when other staging and microstaging attributes are taken into consideration . If appropriate tissue is available, the DOPA reaction |
|
may be positive in at least part of the tumor , and electron microscopy shows some melanosomes and premelanosomes in nearly all cases . However, in practice, these methods have been largely supplanted by immunohistochemical techniques . |
|
Immunohistochemistry. Most of the problems in distinguishing amelanotic or oligomelanotic tumorigenic melanomas from other tumors can be resolved by immunohistochemistry, using a panel of antibodies including 8100, HMB-45, keratin (low and intermediate molecular weight such as AE1/3), and leucocyte common antigen (LCA) . On immunohistochemical testing, 8100 protein is nearly always positive in melanoma . A keratin stain should be done in addition to staining for 8100 protein to rule out not-uncommon 8100positive carcinomas . A few studies have reported positive keratin reactivity in melanomas, but this is unusual when standard methods are used in paraffin sections . Reactivity of melanomas, mostly metastatic, has been described with polyclonal but not monoclonal carcinoembryonic antigen, and occasional melanomas react with the epithelial marker epithelial membrane antigen . Melanomas, unlike most carcinomas, express vimentin, an intermediate filament that is usually associated with mesenchymal tissues . Lymphomas are usually positive with LCA, whereas 8100 and HMB-45 are negative. The anaplastic large cell type of non-Hodgkin's lymphoma, which could present primarily in the skin, is quite likely to be confused with melanoma, and these tumors are usually positive for the CD30 (Ki-1) antigen, as well as LCA (CD45) . Occasional examples of histiocytic tumors such as epithelioid histiocytomas or juvenile xanthogranulomas may be confused with nodular melanomas, especially when foam cells or Touton giant cells are inconspicuous . It has been concluded that Melan-A and tyrosinase markers are sensitive and specific in making the diagnosis of a melanocytic lesion . |
|
8everal more specific but less sensitive antigens, of which the antigen recognized by HMB-45 (gp100) is prototypic, are used in addition to 8100 in making the distinction between melanoma and non melanoma tumors. Like 8100, HMB-45 is positive in many benign melanocytic tumors, and thus it is not specific for melanoma. Its sensitivity of about 70% overall is less than that of 8100, for which the sensitivity is close to 100% but the specificity is low . HMB-45 expression is generally negative in desmoplastic and to a lesser extent other spindle cell melanomas . The specificity of the HMB-45 antigen depends on the context in which it is used. Benign melanocytic lesions that may react with HMB-45 include the junctional component of most nevi and the dermal components of dysplastic nevi, blue nevi, cellular blue nevi, deep penetrating nevi, and 8pitz nevi. Thus, HMB-45 cannot be used to distinguish benign from malignant melanocytic neoplasms. If, on the other hand, the diagnostic differential is between melanoma and carcinoma, lymphoma, or sarcoma, the diagnostic specificity of a positive test is very high, albeit not 100%. Use of HMB-45 has been augmented and in some institutions supplanted by other markers. Melan-A (MART-1) is an antigen initially recognized by T cells in melanoma patients, and, like HMB-45, is associated with the pigmentary apparatus. The sensitivity of this antigen is somewhat greater than that of HMB-45, and its specificity is about the same. The Melan-A antibody labels reactive cases strongly and clearly but is less sensitive in spindle cell melanomas and usually negative in the spindle cells of desmoplastic melanomas . It also must be noted that although Melan-A has more specificity than HMB-45 for detecting cells of melanocytic lineage, it also reacts with normal melanocytes and with nevus cells, limiting its utility as a potential marker for malignancy. Other markers |
|
that have been studied recently include the melanoma-associated antigen (MAGE) series , microphthalmiaassociated transcription factor (MITF) (, and others. In a recent study, Xu et al. evaluated reactivity for altemative markers in 14 HMB-45-negative, nondesmoplastic melanomas . Melanocyte-specific transcription factor was positive in 9, Melan-A in 9, tyrosinase in 6, and MAGE-1 in 11. In 8 desmoplastic malignant melanomas, MAGE-1 was positive in 3, and all other markers were negative. The five markers tested were negative in all but two schwannomas, one with focal melanocyte-specific transcription factor and the other with tyrosinase and weak MAGE-1 reactivity. It was concluded that MAGE-1, melanocyte-specific transcription factor, tyrosinase, and Melan-A may be useful markers in the diagnosis of malignant melanocytic lesions when HMB-45 is negative . In another study, a "pan melanoma cocktail" composed of HMB-45, MART-1, and tyrosinase labeled 98% of all melanomas but only 60% of desmoplastic melanomas, all of which were positive for 8100. The pan melanoma cocktail is more specific than 8100 and might be considered as a complementary marker to polyclonal 8100 antibody, except for desmoplastic melanoma . |
|
The markers discussed in the foregoing provide little information as to the benign or malignant nature of a lesion. However, the pattem of staining with HMB-45 can be of some assistance: melanomas tend to have more diffuse |
|
staining, whereas staining in benign lesions tends to be top-heavy, no doubt reflecting a form of maturation or senescence . In addition, the S100 subunit S100A6 has been of some use in distinguishing between Spitz tumor and melanomas, with a strong and diffuse staining pattern favoring the former . Finally, proliferation markers as well as other nuclear markers such as p53 , cyclin D , ploidy markers , and structures called nuclear organizer regions have been advocated . The most useful of these is Ki-67 (Mib-1). A high Ki67 rate of, say, 10% or more of reactive cells would favor a malignant diagnosis, whereas a low rate of 2% or especially zero activity would favor a benign diagnosis . In our experience, although we often order a Ki-67 study to assess proliferative activity, most diagnostically equivocal tumors fall into the gray zone of Ki-67 reactivity between these cut-points. Other markers have not been studied in sufficient detail for us to recommend their use. |